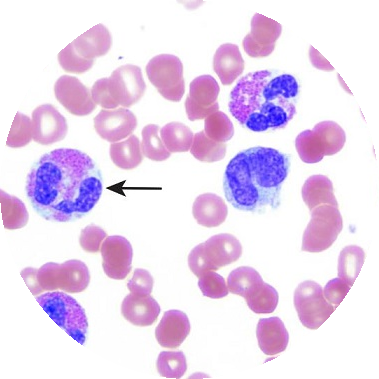
chlamydioza przyczyny

Przyczyny chlamydiozy
Chlamydioza to jedno ze schorzeń wenerycznych, które łatwo jest wyleczyć na początku zarażenia. Niestety, objawy choroby nie zawsze są na tyle charakterystyczne, by móc szybko wdrożyć odpowiednie środki. Warto więc poznać przyczyny choroby, ponieważ wtedy łatwiej jest zapobiegać zarażeniom.
Przyczyna chlamydiozy to bakterie, przenoszące się przy stosunkach seksualnych. Duża liczba zakażeń wynika z tego, iż osoba, która jest nosicielem choroby, często o tym nie wie. Schorzenie może występować bezobjawowo, zarówno u kobiet, jak i u mężczyzn.
Zdarza się także, że dolegliwości występują tylko na początku, w kilka tygodni po kontakcie seksualnym z zarażoną osobą
Wiele osób lekceważy je jednak, co sprawia, że choroba trwa dalej, zwykle aż do momentu, gdy nie spowoduje groźnych powikłań.
Główne przyczyny chlamydiozy
Przyczyny chlamydiozy należy upatrywać również w braku zabezpieczeń. Obecnie nie istnieje skuteczna szczepionka na tę chorobę. Do działań profilaktycznych można zaliczyć ograniczenie liczby partnerów seksualnych oraz zabezpieczanie się poprzez używanie prezerwatywy. Dodatkowo niezbędne jest także wykonywanie badań w kierunku obecności bakterii chlamydiozy. Zazwyczaj poleca się wykonanie testu raz na rok lub pół roku. Jeśli zaś chce się potwierdzić zarażenie po ryzykownym kontakcie seksualnym, konieczne jest zwykle oczekiwanie na objawy choroby (pojawiają się zwykle do dwudziestu jeden dni) wtedy uzyskuje się odpowiednie skierowanie od lekarza.
Szybkie wykrycie chlamydiozy
Obecnie istnieje kilka badań, które pozwalają na wykrycie bakterii chlamydii. Do najbardziej popularnych należą badanie krwi oraz badanie genetyczne. Możliwe jest również wykrycie bakterii na podstawie samego wymazu. Wszystkie te badania muszą być przeprowadzone u lekarza – niezbędne jest przede wszystkim pobranie właściwej próbki. Obecnie można zamówić specjalny zestaw i wykonać badanie samodzielnie, jednak właściwe pobranie próbki może być niemożliwe do wykonania.
Jeśli próbka zostanie pobrana z niewłaściwego odcinka szyjki macicy, wtedy może dać fałszywie negatywny wynik
Powody chlamydiozy u dzieci, to zwykle zakażenie jeszcze w łonie matki. Dlatego też, by zapobiec chorobie, najlepiej jest wykonać badanie w kierunku chlamydiozy jeszcze przed zajściem w ciążę, kiedy możliwości leczenia są szerokie. W przypadku, gdy zakażenie zostanie wykryte dopiero potem konieczna bywa wizyta w szpitalu. Nie można również zastosować maksymalnie skutecznej terapii – skraca się między innymi czas przyjmowania antybiotyku.
Powikłania chlamydiozy
Powikłania w przypadku tej choroby dotyczyć mogą zarówno kobiet, jak i mężczyzn, jednak to właśnie u płci pięknej są one znacznie poważniejsze. Brak swoistych objawów chlamydiozy powoduje, że nie jest ona wykrywana odpowiednio wcześnie. To powoduje, iż powikłania zdarzają się bardzo często. Należą do nich zapalenia cewki moczowej i odbytu. Możliwe są także uszkodzenia jajowodów, które mogą powodować problemy z zajściem w ciążę w przyszłości. Możliwym powikłaniem są także nadżerki oraz nowotwór narządu rodnego. U mężczyzn również występują problemy z oddawaniem moczu oraz zapalenia narządów.
Bibliografia
1. Dziubek Zdzisław, Choroby zakaźne i pasożytnicze, PZWL, 2012
2. H.W. Murray, C. Tuazon, Neumonías atípicas, Clin Med Norteamér, 1980
3. Zofia Grąbczewska, Ludmiła Szymaniak, Ewa Wiśniewska, Romuald Przybył, Grzegorz Grześk, Gwidon Polak, Edmund Nartowicz, Teresa Wodyńska, Jacek Kubica, Haemostatic risk factors in patients with unstable angina and Chlamydia pneumoniae IgA and IgG seropositivity, Kardiol. Pol, 2002








Przyczyny chlamydiozy zawsze są takie same. Przynajmniej w dwóch przypadkach, z którymi się w życiu zetknęłam, zawsze było to samo: brak zabezpieczenia podczas stosunku. Mimo że była to osoba znana od lat, dbająca o higienę – normalny człowiek po prostu. Jeden raz i wystarczyło.
Dwa przypadki chlamydii to żaden materiał porównawczy. Pogadaj z lekarzami dermatologami, którzy chorobami wenerycznymi zajmują się na co dzień. I dowiesz się, że zakażenie wcale nie zawsze jest takie oczywiste. A to ważne, bo potem leczenie chlamydii wcale nie jest takie oczywiste, jak się niektórym udaje.